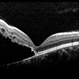
Retinal Detachment Sparing Fovea By Microns Retinal Detachment Sparing Fovea By Microns

-
 By Daniel Davis, OCT-C
By Daniel Davis, OCT-C
The Retina Institute, St. Louis - Uploaded on Nov 29, 2023.
- Last modified by Joshua Friedman on Nov 29, 2023.
- Rating
- Appears in
- Miscellaneous
- Condition/keywords
- multicolor
- Photographer
- Daniel Davis, OCT-C
- Imaging device
-
Optical coherence tomography system
Heidelberg Spectralis - Description
- Multi-color fundus of a 30 yo female with PAMM OD.


 Initializing download.
Initializing download.